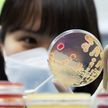

뉴스 · 콘텐츠
韓-가나, 기술·디지털·혁신 개발협력 MOU 체결
프라임경제 03.11
영업익 2위 오른 현대차·기아…혁신기술로 1위 토요타 '정조준'
이데일리 03.11
김홍도 작품, 국장실 소장품 전락...안산교육청, 미술품 전시 '논란'
경기일보 03.11
'K-문샷' 원팀 가동···AI 시대 과학기술 경쟁력 높인다
이데일리 03.11
부처별 흩어진 전략기술 513개 정비…19개 분야로 묶는다
연합뉴스 03.11
술 마시고 차량 6대 들이받은 현직 경찰관 직위해제(종합)
연합뉴스 03.11
DGIST기술지주, 최문종 신임 대표 합류···‘공격적 투자 펀드’ 생태계 재편
이뉴스투데이 03.11
전술 스마트워치의 진화, 가민 ‘택틱스 8 세라코트‘
마리끌레르 03.11
“실전같은 훈련으로”…포천소방서, 2026 상반기 소방전술훈련평가 실시
경기일보 03.11
인천시, 중소기업 기술전환·벤처투자 연계지원 본격 추진
중도일보 03.11
화려한 영상미로 기술을 설득하다…한화그룹 새광고
AP신문 03.11
선박 관리부터 심폐소생술까지…평택해경, 유·도선 종사자 맞춤형 안전교육 실시
경기일보 03.11
흙의 날, 경기도농업기술원 농기계 점검 [포토뉴스]
경기일보 03.11
서울 첫 뉴미디어 미술관 ‘서서울미술관’ 오픈! 꼭 봐야 할 전시 4
마리끌레르 03.11
한수원, 체코전력공사와 청정수소 사업·기술개발 위한 MOU
아주경제 03.11
한국교통대, 베트남 교통기술대서 철도공학 시범 강의
연합뉴스 03.11
인천 건설현장 노동자 30명 식중독 의심 증상…역학조사
연합뉴스 03.11
[금융로드] “기술·데이터로 금융 문턱 낮춘다”…하나금융, 브이원씨와 중소사업자 지원 동맹
뉴스로드 03.11
엑셀라, 과학기술정보통신부 산하 협회 최초 글로벌 인프라 기업으로 참여
경향게임스 03.11
[IPO] 리센스메디컬 "정밀 냉각 기술로 안 아픈 시술 구현…글로벌 의료기기 기업 도약"
프라임경제 03.11